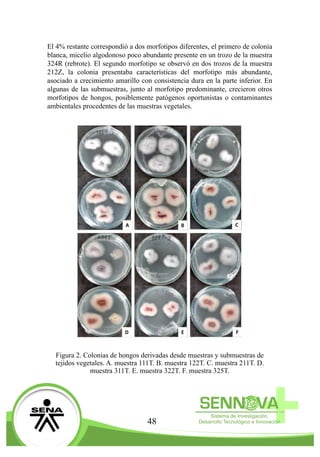
48
El 4% restante correspondió a dos morfotipos diferentes, el primero de colonia
blanca, micelio algodonoso poco abundante presente en un trozo de la muestra
324R (rebrote). El segundo morfotipo se observó en dos trozos de la muestra
212Z, la colonia presentaba características del morfotipo más abundante,
asociado a crecimiento amarillo con consistencia dura en la parte inferior. En
algunas de las submuestras, junto al morfotipo predominante, crecieron otros
morfotipos de hongos, posiblemente patógenos oportunistas o contaminantes
ambientales procedentes de las muestras vegetales.
Figura 2. Colonias de hongos derivadas desde muestras y submuestras de
tejidos vegetales. A. muestra 111T. B. muestra 122T. C. muestra 211T. D.
muestra 311T. E. muestra 322T. F. muestra 325T.

Este documento describe la experiencia de los estudiantes semilleristas integrantes de los Semilleros de Investigación de la Universidad Católica de Oriente desde 2001 hasta 2016. Explica cómo los semilleristas han contribuido a su propia formación a través de la participación en proyectos de investigación, adquiriendo conocimientos y habilidades. También resalta los logros obtenidos por los semilleristas al participar en eventos y las publicaciones generadas como producto de sus investigaciones.





























![30
Pero las transformaciones son discontinuas, los habitantes del mundo somos
esencialmente diversos y plurales (Akara, 2006), por eso todos los ingresos son
diferentes, policromáticos, venimos de mundos diferentes y es por ello que las
llegadas son diferentes.
Vengo de un mundo donde se disponían los espacios según las
responsabilidades de sus gestores. Cada espacio era diferente, con
actividades específicas y acuerdos preestablecidos para diversas
finalidades; así aprendí a ubicarme, sólo tenía que asimilar los límites y
concretar mis intervenciones para permanecer en ese ciclo sistemático,
riguroso y determinado. Había un lugar para comer como los restaurantes,
otro lugar para jugar como el arenero, el deporte se hacía en el coliseo,
la familia se reunía cada fin de semana en la casa de la abuela y un lugar
para aprender: la escuela, de todos, el más importante y tal vez el lugar
más transitado por mi cuerpo. (Mariana Serna Sierra, narración biográfica
en el marco de esta investigación)
La transformación en el ingreso a los semilleros de investigación de Akará está
más adentro, es algo tan profundo que independiente a la edad en la cual se
ingrese hay un cambio en la relación con el conocimiento, cada semillerista trae
su forma de vida del colegio.
Para entonces había adoptado comportamientos pertinentes [con] este
espacio [la escuela] que en mi mente parecía irremplazable; comencé a
dar lo mejor de mí, no sólo por lo mucho que me gustaba, sino porque
debía exponer mi proceso de formación constantemente para recibir un
número, una nota que validara mi esfuerzo y todo lo que la construcción
significaba para mí. Es inevitable reconocer que nunca pareció un método
efectivo, no era lo que esperaba cada vez que contribuía a alimentar este
espacio; entonces entendí que la comparación de esfuerzos opacaba
mis logros, reconocer a otros afectaba y determinaba mi desarrollo, la
competencia llegó sin ser percibida.
Así comencé a retirarme. No sólo me sentía completamente ajena a las
personas que me rodeaban, también sentía que se apartaba el mundo;](https://image.slidesharecdn.com/encuentrosenovafinalimpresion-161229230901/85/Revista-Encuentro-SENNOVA-30-320.jpg)

![53
Referencias
Agrios, G.N. (2001): Fitopatología. UTEHA-Noriega., México. Angulo, C.R.,
Cooman, A., Gómez, D. Fuentes, L.S., Niño, N.
Espinoza, L., Cuellas, J., Medina, A., Escolbar, H. (2006). Lulo: el cultivo.
Fundación Universitaria de Bogotá Jorge Tadeo Lozano. Bogota, pp 39.
Burgess, L. W., Knight, T. E., Tesoriero, L., Phan, H.T. (2008). Diagnostic
manual for plant diseases in Vietnam. Australian Centre for International
Agricultural Research. Camberra.
Delgado, G.P. (2014). Exportaciones de fruta Gulupa crecieron 5 veces
en los últimos seis años. La Republica. http://www.larepublica.co/
economia/exportaciones-de-fruta-gulupa-crecieron-5-veces-en-los-
%C3%BAltimos-seis-a%C3%B1os_106811. (consultado el 09/03/2016)
Escobar, T.W. Cabrera, C.A. (2006). Manual técnico del cultivo de maracuyá
(Passiflora edulis L) en el departamento del Huila. Litocentral. Neiva.
ICA (2011). Instituto Colombiano Agropecuario. Manejo de problemas
fitosanitarios del cultivo de gulupa (Passiflora edulis Sims), medidas para
la temporada invernal. Produmedios. Bogotá.
Leslie, J. F y B. A. Summerell. (2006). The Fusarium Laboratory Manual.
Blackwell Publishing Professional. USA. 388p.
MIP. (2010). Manejo integral de plagas (MIP) Gulupa. http://idbdocs.iadb.
org/wsdocs/getdocument.aspx?docnum=35 536898. (Consultado el
31/05/2016)
Ortiz, E. (2012). Etiología de enfermedades asociadas a fusariosis en el cultivo
de gulupa (Passiflora edulis Sims) en la región de Sumapaz. [Tesis de
maestría]. Universidad Nacional de Colombia. Bogotá.](https://image.slidesharecdn.com/encuentrosenovafinalimpresion-161229230901/85/Revista-Encuentro-SENNOVA-53-320.jpg)










![64
Asthon, O.B., Wong, M., McGhie, T.K., Vather, R., Wang, Y., Jackman, C.R.,
Ramankutty, P., & Wolf, B.A. (2005). Pigments in Avocato Tissue and Oil.
Journal of Agricultural and Food Chemistry. 54, 10151-10158
Cano, L.A. (2011). Extracción y uso de tres pigmentos naturales a partir de
tomate
de árbol (Solanum betaceum Cav.), mortiño (Vaccinium myttillus L.) y mora
de castilla (Rubus glaucus) como alternativa colorante natural para alimentos.
[Trabajo de grado]. Escuela Politécnica Del Ejército. Sangolqui
Dabas,D.,Elias,R.J.,Lambert,J.D.,&Ziegler,G.R.(2011).AColoredAvocado
Seed Extract as a Potential Natural Colorant. Journal of Food Science,
76(9), 1335–1341. http://doi.org/10.1111/j.1750-3841.2011.02415.x
Devia, J.E., & Saldarriaga, D.F. 2005. Proceso para obtener colorante a partir
de la semilla de aguacate. REVISTA Universidad EAFIT, 41 (137), 36-43.
Díaz, L. S., Padilla, C., Sepúlveda, C. (2006). Identificación del Principal
Pigmento Presente en la Cáscara del Maracuyá Púrpura (Passiflora edulis).
Información Tecnológica, 17(6), 75–84. http://doi.org/10.4067/S0718-
07642006000600013
Guanying, Z. (2015). Passion fruit extraction method Pigment. CN103952012
(CO9B 61/00; CO9B 67/54). 14 Oct 2015. Appl 201410179090 30 April
2014. 5p
Guirola, C., (2010). “Tintes naturales: su uso en Mesoamérica desde la época
prehispánica”, FLAAR, Mesoamérica.
Kha, T.C., Phan-Tai, H., Nguyen, M.H. (2014). Effects of pre-treatments on the
yield and carotenoid content of Gac oil using supercritical carbon dioxide
extraction. Journal of Food Engineering 120, 44–49
Kidøy, L., Nygard, A.M., Andersen, O.M., Pedersen, A.T., Aksnes, D.W.,
Kiremire, B.T. (1997). Anthocyanins in Fruits of Passiflora edulis and P.
suberosa. Journal of Food Composition and Analysis, 54, 49–54. http://
doi.org/10.1016/S0031-9422(00)84657-9
Mercadante, A.Z., Britton, G., Rodríguez, D.B. (1998). Carotenoids from
yellow passion fruit (Passiflora edulis). Journal of Agricultural and Food
Chemistry, 46, 4102-4106
Prado, J.M., Vardanega, R., Debien, I.C., Almeida, M.A., Gerschenson,
L.N., Sowbhagya, H.B., Chemat, S. (2015). Conventional extraction.](https://image.slidesharecdn.com/encuentrosenovafinalimpresion-161229230901/85/Revista-Encuentro-SENNOVA-64-320.jpg)
![65
En Galanakis, C.M. Food Waste Recovey Processing Technologies and
Industrial Techniques (pp. 127-148). United States of America. Elsevier
Inc.
Polania, B.W. (2014). Actividad antioxidante de los residuos del aguacate Hass
(Persea americana Mill. var Hass) sometidos a extracciones clásicas y
a fluidos presurizados. [Tesis de Maestría]. Universidad Nacional de
Colombia. Bogotá
Pruthi, J.S., Susheela, R., Lal, G., (1961). Anthocyanin pigment in passion fruit
rind. Journal of Food Science. Volume 26, Issue 4, 385–388
Schoefs, B. (2003). Chlorophyll and carotenoid analysis in food products. A
practical case-by-case view. Trends inAnalytical Chemiestry. 22 (6). Wang,
W., Bostic, T. R., & Gu, L. (2010).Antioxidant capacities, procyanidins and
pigments in avocados of different strains and cultivars. Food Chemistry,
122(4), 1193–1198. http://doi.org/10.1016/j.foodchem.2010.03.114
Tsao, R. (2010). Chemistry and Biochemistry of Dietary Polyphenols. Nutrients
2010, 2, 1231-1246; doi:10.3390/nu2121231
Wang, W., Bostic, T. R., & Gu, L. (2010). Antioxidant capacities, procyanidins
and pigments in avocados of different strains and cultivars. Food Chemistry,
122(4), 1193–1198. http://doi.org/10.1016/j.foodchem.2010.03.114
Wong, Y.S., Sia, C.M., Khoo, H.E., Ang, Y.K., Chang, S.K., Yim, H.S. (2014).
Influence of extraction conditions on antioxidant properties of passion
fruit (Passiflora edulis) peel. Acta Scientiarum Polonorum, Technologia
Alimentaria. 13. 257-265.
Zeng, S., Bin, P., Baodong, Z., Fang, D., Jie, C. (2013). Extracting method
of passion flower fruit pigment. CN102757664B. (C09B 61/00). 13 nov
2013. Appl 201210226177 3 jun 2012. 6p](https://image.slidesharecdn.com/encuentrosenovafinalimpresion-161229230901/85/Revista-Encuentro-SENNOVA-65-320.jpg)






























![96
AIFS Arbitration Inter-Frame Space, así las AC con una baja prioridad tienen un
AIFS mayor y tendrán que esperar más tiempo para empezar a transmitir, caso
contrario las AC con mayor prioridad tienen un tiempo AIFS menor y podrán
transmitir antes.
En cuanto a las ventanas de contención ocurre algo similar, el rango de la ventana
de contención [CWmin,CWmax] es diferente para cada AC, las AC con altas
prioridades tienen tiempos de espera más pequeños.
Para conseguir la diferenciación del tráfico se definen diferentes tiempos de
acceso al medio y diferentes tamaños de la ventana de contención para cada una
de las categorías.
Al definir prioridades para los paquetes en capas superiores se utiliza el estándar
IEEE 802.1P, según este estándar existen 8 niveles de prioridad diferente,
entonces estos 8 niveles se asociaran a las cuatro AC que define EDCA en capa
MAC.
De esta manera el estándar IEEE 802.11e es una alternativa viable para mitigar
los inconvenientes en la transmisión de tráfico multimedia en redes inalámbricas
pues permite la priorización de los paquetes y la implementación de servicios
diferenciados.
4 Resultados parciales consideraciones sobre el estándar
IEEE 802.11e
Las técnicas de acceso al medio utilizadas en el estándar IEEE 802.11 le dan la
posibilidad a las redes inalámbricas WIFI de diferenciar y priorizar el tráfico y
de esta manera es posible implementar arquitecturas para proveer QoS.
Desde el desarrollo del estándar han surgido múltiples trabajos en los cuales
se pretende validar el mismo utilizando ambientes de simulación, en el estudio
realizado por Rauf, Amjad y Ahmed (2009) se efectúa una comparación entre
IEEE 802.11 y IEEE 802.11e utilizando herramientas de simulación, los
resultados de la evaluación de IEEE 802.11e EDCA en comparación con los
estándares IEEE 802.11 DCF. Indican que el protocolo IEEE 802.11e introduce
en forma eficaz los mecanismos de diferenciación, con el fin de proporcionar
QoS en una solución de red inalámbrica.](https://image.slidesharecdn.com/encuentrosenovafinalimpresion-161229230901/85/Revista-Encuentro-SENNOVA-96-320.jpg)

















